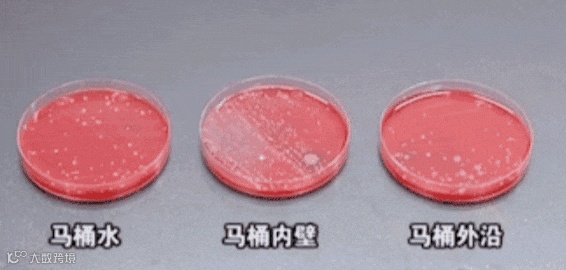

马桶是否洁净无异味,真的能看出一个家庭的清洁程度。
但不管你冲厕多及时,时间久了马桶上总会有一层恶心的黄垢...

很多做家务人士宁愿洗100次碗也不愿刷一次马桶,看着恶心,闻着臭。
弯腰靠近它时,那个味道真是绝了……

有时候想喷点香水遮盖一下,结果香臭香臭的,那滋味……
不知道的还以为家里开了个臭豆腐加工厂!

更可怕的是还有很多不见的细菌在对你虎视眈眈,央视《原来如此》的节目曾对此做过实验:
刚刷完的马桶仍有10万个细茵!如大肠杆箘、痢疾杆箘、金黄色葡萄球箘...
而且每次冲马桶时,这些微生物会在水的冲力下产生漩涡,并形成气溶胶喷溅出来,落在你的厕纸、毛巾表面。

若不加以重视任由其严重下去,甚至会引发皮肤病、妇科炎症、呕吐不止等各种疾病。
严重影响人们的身体健康!

特别是家里有小朋友的就更要注意马桶的清洁了!
据世界卫生组织近期整理的数据来看:约有190万人因马桶附着菌引发病痛,其中34%的患者为3-7岁儿童!

为了给马桶清洁杀菌、除味除臭,我们买了各种洁厕用品:蓝泡泡、洁厕灵轮番上阵!
可是除了容易产生挂壁现象味道刺鼻不说,还特别容易腐蚀马桶!

强烈推荐这款马桶自动清洁神器
【GRAREY格瑞亚-马桶清洁凝胶】
✅免刷洗,120秒瓦解污渍
✅99.9%除菌率,高效清洁
✅浓稠凝胶,持久挂壁
✅温和配方,不伤釉面
✅弯头设计,清洁更方便
1瓶=杀菌➕除垢➕光亮➕除味❗️尿渍、污渍、黄斑、霉垢等,无需动手随手一倒自动去除~



【GRAREY格瑞亚-马桶清洁凝胶】
🔺免刷洗解放双手
🔺浓稠凝胶持久挂壁
🔺高效清洁不伤马桶
用完就像换了新马桶一样~



1瓶=杀菌➕除垢➕光亮➕除味❗️
🔺免刷洗,快速溶解污垢
🔺2分钟强力去污
🔺99.9%除菌率
🔺浓稠凝胶,持久挂壁
🔺温和配方,不伤釉面不伤手
🔺弯头设计,不留死角
🔺操作简单,省时省力




✅免刷洗,快速除垢
传统的洁厕产品
要么需要动手要么清洁力差❌
包括同类型的洁厕凝胶
我们实测后可以看出
不动手完全没有清洁力❌
而GRAREY马桶洁厕凝胶
同样的“污垢”同样的时间
无需动手在液体流动过程中
🔺就能看到逐渐在自动溶解
非常适合懒人的一款清洁神器❗️




✅2分钟强力去污
用油笔模仿马桶污渍
倒上我们的洁厕凝胶
冲水瞬间变干净❗️
肉眼可见的清洁效果
无需刷洗0残留
120秒快速瓦解污渍
吊打市面上90%马桶清洁剂👍


✅浓稠凝胶,持久挂壁
肉眼可见的高浓稠❗️
普通液体洁厕剂跟水一样❌
不挂壁丨流动快丨清洁性差❌
而GRAREY洁厕凝胶
✅浓稠凝胶丨持久挂壁丨自动清洁
✅可以深入瓦解顽固污渍
轻松祛除尿渍、污渍、黄斑等
日常污渍无需动手刷洗
可以持久附着管道表面
还能起到养护马桶的效果



✅强力除垢因子
之所以能有如此优秀的清洁力
是因为凝胶含有强力去垢因子
无需动手即可快速去污
即使是陈年黄垢
倒进去静置一段时间后
也能轻松溶解污垢
杯子瞬间干净透亮无残留❗️

✅99%除菌率
权威机构检测认证
针对金黄色葡萄球菌、大肠杆菌等
可灭杀率高达99%
从源头就能杀灭细菌
分解异味蹲厕更安心




✅温和配方
不伤釉面不伤手
不会腐蚀地板
无刺激性味道
还能清新空气去异味
不小心弄到手上也没关系
有老人家庭的小孩皆可放心使用




✅600g大容量
不同于蓝泡泡、洁厕灵顶多用半个月
600g升级大容量
需要时倒一些
无需动手刷洗就能拥有干净马桶
一大瓶能用好久



✅弯头设计
瓶口采用弯头设计
方便接触凹槽
360度清洁死角
可以滋进去卫生死角
凹槽处都能干净如新



✅操作简单
只需轻轻挤压瓶身
将洁厕凝胶喷到有污垢的地方
就会自动慢慢溶解污渍
一冲即净❗️免刷❗️
顽固污渍也能干净如新
📍Tips:建议重度污垢增加用量静置10分钟以上,搭配刷子使用效果更好哦~



不仅可以适用于马桶
蹲厕、瓷砖缝隙等皆可使用
轻轻一倒一冲洗
杀菌除臭又干净
每次清洁相当于一次杀菌
真正意义上的干干净净
贴心守护全家人健康~






